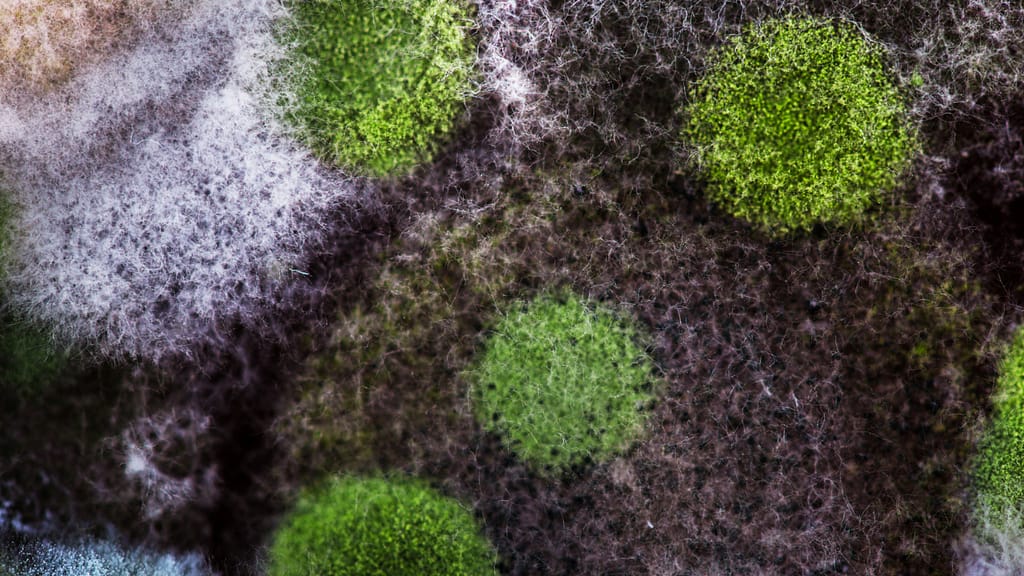
Carpet bacteria and viruses

Carpet Bacteria and Viruses: How Steam Cleaning Keeps Your Home Safe
Carpets are cosy and warm underfoot, but they also act like sponges for dust, spills, pet dander and — importantly — carpet bacteria and viruses. For households worried about hygiene and health, understanding the risks and the role of professional cleaning is essential. This article explains the health risks of dirty carpets, how steam cleaning works, and why many homeowners choose to sanitize carpets with steam cleaning to protect their family.
Why carpets harbour bacteria and viruses
Carpet fibres trap microscopic particles that float through indoor air: skin cells, food crumbs, pet saliva, and environmental pollutants. These provide nutrients and moisture pockets where microorganisms can survive. High-traffic areas and rooms with pets or children will show the greatest buildup. Over time this accumulation increases the health risks of dirty carpets — from mild skin irritation to more serious respiratory or infection concerns for vulnerable people.
Common health issues linked to contaminated carpets
- Skin irritations and rashes: Residues, bacteria and chemical residues in carpets can provoke contact dermatitis or worsen sensitive skin.
- Allergic reactions: Dust mites, pet dander and mould spores trigger sneezing, itchy eyes and eczema flare-ups.
- Respiratory problems: Fine particles and microbes embedded in fibres can reduce indoor air quality and aggravate asthma.
- Infection risk: While viruses don’t usually multiply in carpets, they can survive long enough to be transferred by contact, especially with high viral-load spills.
How steam cleaning works: more than just hot water
Many people ask, “does steam cleaning disinfect carpets?” The answer is: it can — when done properly. Professional steam cleaning (hot water extraction) injects very hot water and detergent into the pile, then extracts it along with loosened soil. The high temperatures — often above 70–80°C at the point of contact — combined with mechanical agitation and powerful extraction, significantly reduce bacteria and inactivate many germs. When technicians use EPA-registered sanitizers or disinfectants designed for textile use as part of the process, effectiveness increases.
Steam cleaning vs routine vacuuming
Vacuuming removes dry debris and reduces allergen load, but it can’t reach deep-seated microorganisms or oily residues. In contrast, steam cleaning reaches down into fibres, lifting and removing contaminants. For families asking whether to vacuum or call a pro, the best approach is both: regular vacuuming combined with periodic professional steam cleaning to sanitize carpets with steam cleaning and keep microbial levels low.
Steam cleaning carpets to kill germs: real benefits
When properly executed, steam cleaning carpets to kill germs offers multiple benefits:
- Reduces bacterial counts and can inactivate many viruses by heat and extraction.
- Removes allergens (dust mites, pollen, pet dander) that cause skin and respiratory symptoms.
- Eliminates food residues and organic matter that feed microbes, lowering re-contamination risk.
- Improves indoor air quality, which helps prevent skin irritation linked to dust and irritants.
Best practices for safe, effective steam cleaning
To maximize germ reduction and minimise the health risks of dirty carpets afterwards, follow these tips:
- Choose a reputable cleaner who uses hot-water extraction and adjustable heat settings.
- Ask whether they use textile-safe sanitizers or disinfectants appropriate for carpets.
- Ensure adequate drying — carpets should dry within 6–12 hours to prevent mould growth.
- Schedule professional cleaning every 6–12 months, or more often in homes with pets, allergies, or young children.
When to consider additional sanitizing measures
In situations of spills with bodily fluids, infectious illness in the home, or persistent odours, an enhanced sanitizing protocol is wise. Professional teams can apply safe disinfectants after steam cleaning to further reduce microbial risk. That said, always use products intended for carpets and follow label instructions — overuse of harsh chemicals can themselves cause skin irritation.
Conclusion — keeping your home safe and comfortable
Understanding carpet bacteria and viruses helps homeowners make informed decisions. While no cleaning method eliminates every microbe, the combined action of heat, detergent and extraction makes steam cleaning a powerful tool. If your concern is preventing skin irritations and protecting indoor health, a planned program of regular vacuuming plus professional steam cleaning to sanitize carpets with steam cleaning is one of the most effective steps you can take.
Book a professional steam cleaning
Why Choose Rezel Carpet Care?
With years of experience serving Melbourne residents, we understand the unique cleaning challenges faced by local homes and businesses. Our expert team uses state-of-the-art steam cleaning technology to deep clean and sanitize your valuable furnishings.
Ready to Experience Professional Carpet Steam Cleaning?
Contact us today for a free quote and discover the difference professional steam cleaning can make!